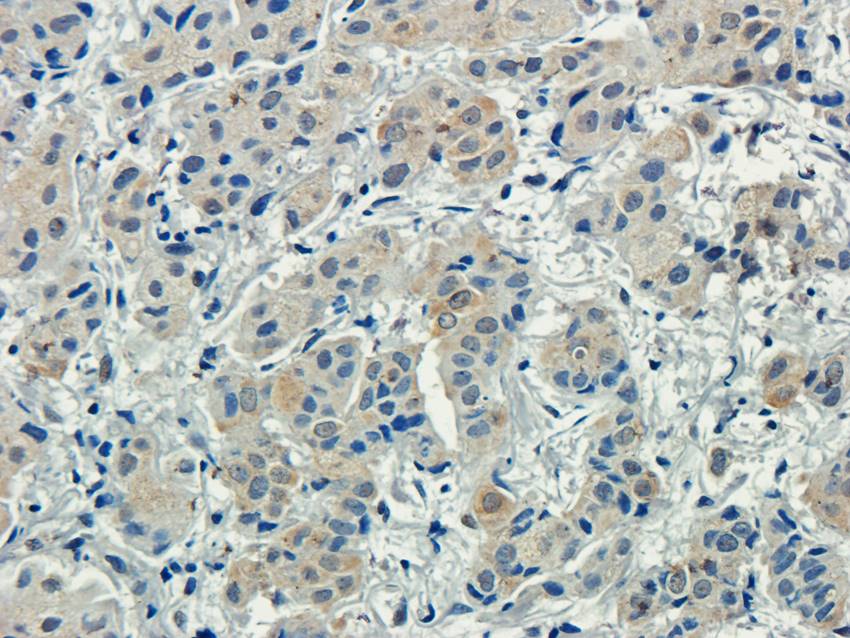
产品细节图片2
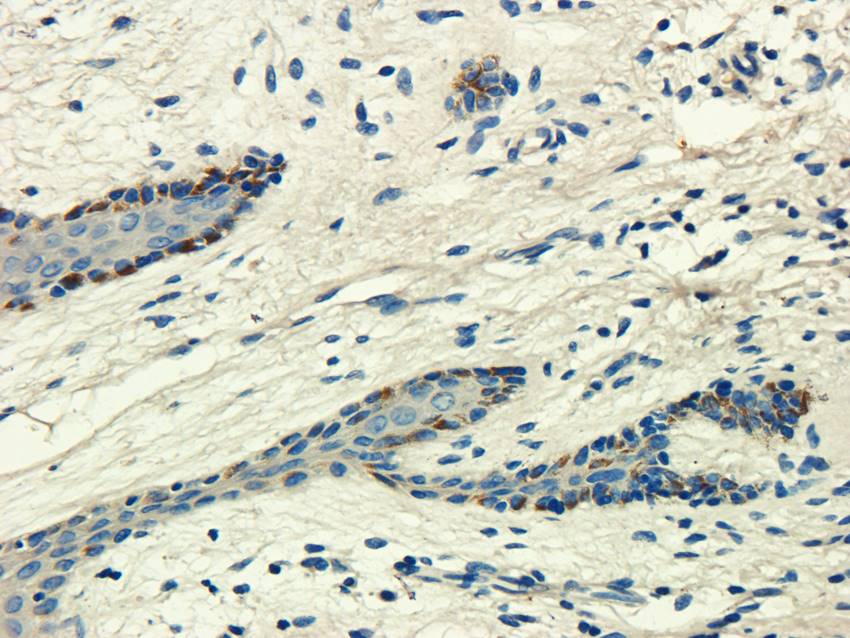
产品细节图片3

相关产品推荐更多 >
万千商家帮你免费找货
0 人在求购买到急需产品
- 详细信息
- 文献和实验
- 技术资料
- 抗体名:
CD155 antibody抗体
- 抗体英文名:
CD155 antibody
- 靶点:
CD155
- 浓度:
- 100 μg (in 200 μl): 0.5 mg/ml- 200 μg (in 400 μl): 0.5 mg/ml
- 应用范围:
IHC-P, WB
- 宿主:
Rabbit
- 适应物种:
Human, Mouse, Rat
- 保质期:
6-12个月
- 抗原来源:
详询
- 目录编号:
orb13359
- 级别:
科研级
- 库存:
88
- 供应商:
biorbyt
- 标记物:
Unconjugated
- 克隆性:
Polyclonal
- 形态:
10 mM PBS, 0.02% sodium azide
- 亚型:
IgG
- 免疫原:
KLH conjugated synthetic peptide derived from human CD155. Please contact us for the exact immunogen sequence. The peptide is available as orb12907.
- 规格:
100 ug
别名:anti-CD155 antibody, anti-CD155 antigen antibody, anti-FLJ25946 antibody, anti-HVED antibody, anti-mE4 antibody, anti-NECL 5 antibody, anti-Necl-5 antibody, anti-Necl5 antibody, anti-Nectin like 5 antibody, anti-Nectin like protein 5 antibody, anti-Nectin-like protein 5 antibody, anti-Ortholog of mouse Tage4 antibody, anti-Poliovirus receptor antibody, anti-PVR antibody, anti-PVR_HUMAN antibody, anti-PVS antibody, anti-Taa1 antibody, anti-Tage 4 antibody, anti-TAGE4 antibody
免疫原:KLH conjugated synthetic peptide derived from human CD155. Please contact us for the exact 免疫原 sequence. The peptide is available as orb12907.
分子量:45 kDa
应用稀释比例:IHC-P: 1:50-400, WB: 1:200-1000
纯度:Polyclonal antibodies are purified by peptide affinity chromatography
保存说明:Maintain refrigerated at 2-8°C for up to 2 weeks. For long term storage store at -20°C in small aliquots to prevent freeze-thaw cycles.
NCBI:31, 006496, 006505
Entrez:5817
UniProt ID:P15151
Note:For research use only.

风险提示:丁香通仅作为第三方平台,为商家信息发布提供平台空间。用户咨询产品时请注意保护个人信息及财产安全,合理判断,谨慎选购商品,商家和用户对交易行为负责。对于医疗器械类产品,请先查证核实企业经营资质和医疗器械产品注册证情况。
文献和实验人可溶性CD155分子(sCD155)ELISA试剂盒 说明书
人可溶性CD155 分子 ( sCD155 )ELISA 试剂盒 ( 用于血清、血浆、细胞培养上清液和其它生物体液内 ) 原理 本实验采用双抗体夹心 ABC-ELISA 法。用抗人 sCD155 单抗包被于酶标板上,标准品和样品中的 sCD155与单抗结合,加入生物素化的抗人 sCD155 ,形成免疫复合物连接在板上,辣根过氧化物酶标记的 Streptavidin 与生物素结合,加入底物工作
mcstudent 我打算找mir-155的靶基因,在网站上是这样的,求高人指导:在http://www.mirbase.org/ 网站上输入 [img]file:///C:/Documents%20and%20Settings/Administrator/Application%20Data/Tencent/Users/270756706/QQ/WinTemp/RichOle/XQ0[%7DYQF_~G$2M)DGF(2CWK.jpg
流式课堂 | 易被忽略的 CD4、CD8 共表达细胞——胸腺淋巴细胞
做过流式实验的同学,对 CD4、CD8 这两个指标都不会陌生。检测 CD4+ T 细胞和 CD8+ T 细胞分型,是流式中最常见的实验之一。 通常,我们会先检测 CD3,来圈总T淋巴细胞,再分别用 CD4 抗体和 CD8 抗体,来区分 CD4+ T 淋巴细胞(辅助或调节性T细胞)和 CD8+ T 淋巴细胞(细胞毒性 T 细胞)。 新生小鼠脾脏细胞 上图为新生小鼠脾脏细胞进行的 CD3-PE、CD4-FITC、CD8-APC 三色流式实验结果。从图中可以看出,在新生小鼠脾脏中,绝大
技术资料暂无技术资料 索取技术资料










